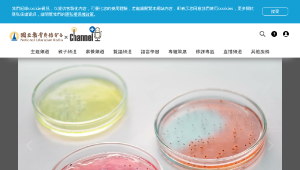

:::
吹彈可破的皮膚人人渴望,皮膚的美白及修復相信也是很多聽眾關心的議題。
台灣與美國之地區人種,多屬於黃種或白種人,經太陽紫外線曝晒後,相較於深色系皮膚者易產生雀斑或黑斑等,更甚則會造成皮膚之病變而衍生為皮膚癌。
目前歐盟已正式立法禁止動物實驗於化粧品項上,各國為因應此一情況,均在找尋可替代的研究平臺。由國立中興大學生醫工程研究所王惠民教授帶領的研究團隊,製作了一種適於各類細胞生長的生醫材料,創新奈米水凝膠技術,研發的成果可有效應用於皮膚組織修復。此一傑出研究並榮獲2021未來科技獎項。
「奈米水凝膠技術」從食用生薑中純化得到的化合物,可很好的促進人類皮膚細胞再生;從香桂抽取出的組合物有優秀的美白效果,勝過現在市面上其他常見的美白成分;玉蘭花精油則以天然抗菌活性抑制傷口上菌株生長,防止皮膚在復原的過程中受到感染。未來產業可應用在醫美手術後修復用醫療產品、各式機能性食品、功能性飲品、化妝品開發保養品原料。
「新科技大未來」節目中,特別邀請王惠民教授為大家分享皮膚美白專利的研發特色,以及皮膚組織修復上傑出的研發成就。歡迎大家一起收聽!
資訊
領域:科技領域-生活科技
學習階段:高中10-12年級(五)
學習內容:*生 A-Ⅴ-7 新興科技應用。
科技教育
B2 科技資訊與媒體素養
未定義
著作權所有
2023-12-29
教學資源檔案連結
資源評論或心得分享
相關資源
其他人也看了這些資源